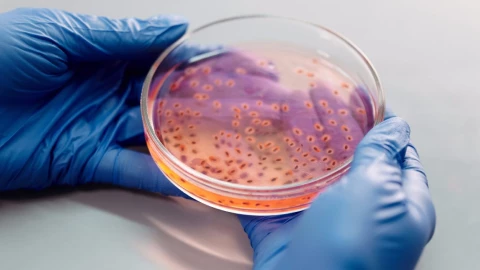
bacterias recipiente estudio

Recientemente se realizó un estudio en el que un grupo de científicos internacionales se encargaron de investigar los relojes biológicos de algunas especies de bacterias no fotosintéticas, las cuales mostraron resultados asombrantes en relación a los factores externos del medio ambiente.
De acuerdo con la investigación publicada en Science Advances, los expertos indicaron que este tipo de bacterias cuentan con relojes internos diarios que se acoplan y alinean con el ciclo de las 24 horas de la Tierra, un comportamiento que también se puede observar en otros seres vivos que vive en el planeta.
BACTERIA - Humans have them, so do other animals and plants - now research reveals that bacteria too have internal daily clocks that align with the 24-hour cycle of life on Earth https://t.co/uC1dj7Eya7 @ant_dodd @MarthaMerrow @EvolvedBiofilm
— John Innes Centre (@JohnInnesCentre) January 8, 2021
Los autores del estudio señalaron que este reloj biológico, también conocido como ciclo circadiano, brinda las facilidades a los seres vivos de adaptarse a su entorno a partir de ciertos factores externos que se presentan tanto en el día como en la noche, así como en las diferentes estaciones del año.
Para realizar esta investigación, los académicos se dedicaron a estudiar el comportamiento y la estructura del microorganismo Bacillus subtilis; fue así que utilizaron una de sus enzimas bioluminiscente con la que lograron ver su actividad y la respuesta genética de este frente a diferentes ciclos de luz y temperatura.
El gen ytvA, que se encarga de codificar el fotorreceptor de luz azul, y la enzima KinC, que está involucrada en la formación de biopelículas y esporas, fueron los principales factores de estudio y, a partir de estos, los científicos se percataron que, los patrones estables de la bacteria se ajustaban a estímulos de luz y temperatura.
Martha Merrow, coautora del estudio, señaló que las bacterias no fotosintéticas son posibles de dar la hora debido a que adaptan su funcionamiento molecular a la hora del día, según leen los ciclos de la luz natural o la temperatura del medio ambiente en el que se encuentren.
La noticia por todos los medios. Descarga nuestra app